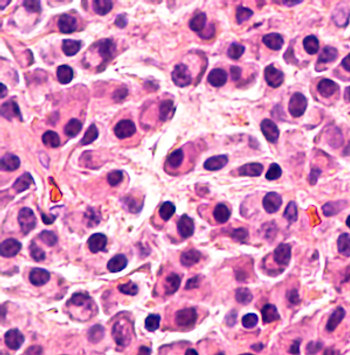

Today, the FDA approved elotuzumab (Empliciti), an injection for intravenous use in combination with pomalidomide and dexamethasone (EPd) for the treatment of adult patients with multiple myeloma who have received at least 2 prior therapies.
Today, the FDA approved elotuzumab (Empliciti), an injection for intravenous use in combination with pomalidomide and dexamethasone (EPd) for the treatment of adult patients with multiple myeloma who have received at least 2 prior therapies.

Earlier this week, the FDA approved pembrolizumab (Keytruda) in combination with carboplatin and either paclitaxel or nab-paclitaxel for the first-line treatment of patients with metastatic squamous non-small cell lung cancer (NSCLC).

Researchers looked to evaluate predictors of mortality in patients with COPD after 9 years.

A recent trial sought to assess the effect of palbociclib on overall survival (OS) and the efficacy of subsequent therapy in patients with hormone receptor–positive (HR+), HER2-negative advanced breast cancer.

A phase 3 trial recently investigated if nanoparticle albumin-bound paclitaxel enhances the treatment of atezolizumab in unresectable locally advanced or metastatic triple-negative breast cancer.

A recent study looked to use real-world data to support the value of pathway regimens designed to create high-quality, affordable treatment in breast cancer care.



Last week, Bristol-Myers Squibb announced results from the phase 3 CheckMate -331 trial that investigated nivolumab (Opdivo) versus the current standard of care, chemotherapy, in the treatment of patients with small cell lung cancer (SCLC) who relapsed following platinum-based chemotherapy. The trial found that nivolumab did not significantly increase overall survival compared with chemotherapy.

Over the past decade, both recreational and medical marijuana use in the United States has grown tremendously. However, disputes surrounding the legal and ethical implications, safe administration, dispensing, health consequences, and therapeutic indications– albeit based on very limited clinical data– related to its usage abound.

Here are 5 breast cancer risk factors for Breast Cancer Awareness Month.

This week, the National Comprehensive Cancer Network (NCCN) published new guidelines for patients centered around neuroendocrine tumors.

Last week, the FDA granted approval to immune checkpoint inhibitor cemiplimab-rwlc, to be sold as Libtayo, for the treatment of metastatic cutaneous squamous cell carcinoma (CSCC), or in patients with locally advanced CSCC who are not candidates for curative surgery or curative radiation.

In a study presented at the American Society of Clinical Oncology Quality Care Symposium last month, researchers looked to assess the adherence to National Comprehensive Cancer Network (NCCN) guidelines in the neoadjuvant treatment of breast cancer and the impact on outcomes.

A recent retrospective analysis examined changes in diagnosis after a second opinion for patients with breast cancer from a multi-disciplinary tumor board review at a National Cancer Institute-designated cancer center.

Two studies presented at the American Society for Bone and Mineral Research 2018 Annual Meeting last month specifically addressed men’s bone health and compared their risks with those of women.

Earlier this week, 3 studies were released that investigated the financial difficulties seen in patients living with cancer. Such difficulties are referred to as “financial toxicity,” which was studied in patients with metastatic breast cancer and older patients, as well as the conversations about cost of care that women with breast cancer have with their physicians.

Earlier this week, drug manufacturer Astrazeneca announced the results from a phase 3 trial studying durvalumab (Imfinzi) among patients with stage III unresectable non­–small cell lung cancer (NSCLC) who did not have disease progression after concurrent chemoradiotherapy.

Although many different treatments exist for basal cell carcinoma (BCC), many methods have not been compared in head-to-head randomized trials. A review recently published in Annals of Internal Medicine looked to evaluate the comparative effectiveness and safety of treatments in adults with BCC.

Last week, the FDA granted priority review to a new supplemental Biologics License Application for pembrolizumab (Keytruda) as a monotherapy for first-line treatment of locally advanced or metastatic nonsquamous or squamous non–small cell lung cancer (NSCLC) in patients whose tumors express PD-L1 without EGFR or ALK mutations.

A recent report from the National Comprehensive Cancer Network (NCCN) investigated the current state of chimeric antigen receptor (CAR) T-cell therapy and future strategies to consider as the novel immunotherapy evolves and is used in the treatment of more patients.

The National Comprehensive Cancer Network (NCCN) released this week new treatment guidelines for patients for 2 uterine cancers, endometrial cancer, the most common gynecologic cancer, and a rare cancer called uterine sarcoma.

Pembrolizumab (Keytruda) earned European approval this week, in combination with platinum-based pemetrexed, for the first-line treatment of metastatic nonsquamous non-small cell lung cancer (NSCLC) in adults whose tumors lack EGFR or ALK mutations.

A team of multi-institutional clinicians and scientists have recently published the first-ever guidelines for the evaluation and treatment of perimenopausal depression, endorsed by the International Menopause Society, in Menopause and the Journal of Women’s Health.

A recent review of nearly 582,000 heart attack cases over the span of 19 years found that female patients had a significantly higher survival rate when treated by a female physician in the emergency department.

A study recently found that an immunotherapy combination treatment of ipilimumab (Yervoy) and nivolumab (Opdivo) shrank melanoma that had spread to the brain in more than half of participants.

It’s been more than 100 days since President Trump and HHS Secretary Alex Azar announced the “American Patients First” drug pricing blueprint. Here are 5 actions the government has taken since its release.

Only 1 day after the European Commission approved CAR T-cell therapies, the National Institute for Health and Care Excellence deemed the treatment too expensive to justify on Britain's state-funded health service.

A recent study at Johns Hopkins Bloomberg-Kimmel Institute for Cancer Immunotherapy discovered a new way to use bioinformatics to determine how a patient’s immune system responds to immunotherapy.

Earlier this month, the National Comprehensive Cancer Network (NCCN) released new treatment guidelines for a group of rare cancers that impact women during pregnancy.

259 Prospect Plains Rd, Bldg H
Cranbury, NJ 08512
© 2025 MJH Life Sciences®
All rights reserved.
